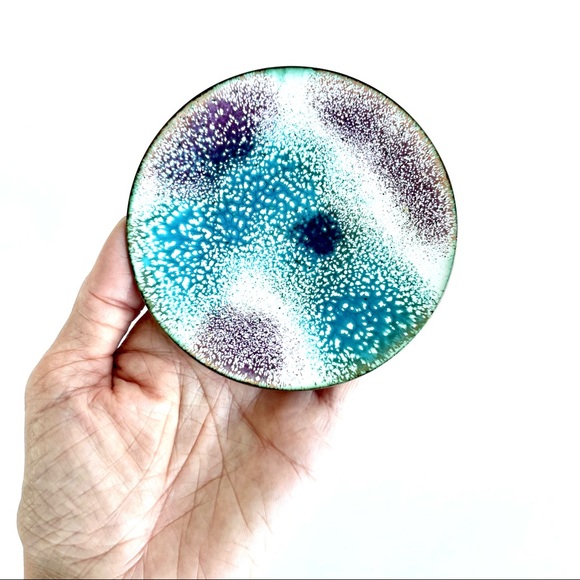
Vintage Enamelled Copper Trinket Dish - Picture 7 of 15

Vintage Enamelled Copper Trinket Dish
C$24
Size
Like and save for later
Add To Bundle
Vintage Enamelled Copper Trinket Dish.
Beautiful white, purple, teal, green, and dark indigo colours. Great for storing jewelry. Makes a perfect gift! There are more enamelled trinket dishes listed in my closet. BUNDLE them together to make a set and SAVE!
Perfect vintage condition. No flaws. Please see the photos for details.
This listing is for one dish only. Jewelry not included.
*OFFERS WELCOME!*
Shipping/Discount
Trending Now
Find Similar Listings
Account is under Review
Comment posting is temporarily restricted. Our team will reach out to you shortly. To understand why, select
Learn More.